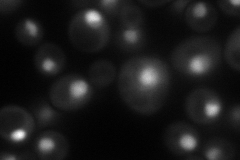
YGL244W
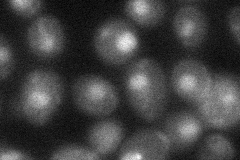
YGL244W

View description
Subunit of the RNA polymerase II-associated Paf1 complex; directly or indirectly regulates DNA-binding properties of Spt15p and relative activities of different TATA elements; involved in telomere maintenance
Localization:
Intensity:
Fold change:
Significance:
-
C’ GFP library in SD

nucleus55.54 -
N' NOP1pr-GFP in SD
cytosol,nucleus97.7497 -
N' TEF2pr-mCherry in SD

cytosol,nucleus10.2824 -
N' NATIVEpr-GFP in SD

nucleus73.2635 -
N' TEF2pr-VC and Cyto-VN in SD
nucleus31.4413 -
C’ GFP library in SD+DTT

nucleus49.70.89No -
C’ GFP library in SD+H2O2

nucleus66.041.18No -
C’ GFP library in Starvation Media

nucleus60.791.09No -
C’ GFP library on the background of Pup2-DaMP

nucleus -
C’ GFP library on the background of CCT mutant

nucleus61.76551.11191No
